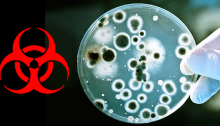

BIG PHARMA: The Depression Pill Epidemic – By Dr. J. Mercola
Source – wakingtimes.com – “…It’s not only that physicians are prescribing more, the population is demanding more. Feelings of sadness, the stresses of daily life and relationship problems can all cause feelings of upset or sadness that may be passing and not last long. But Americans have become more and more willing to use medication…